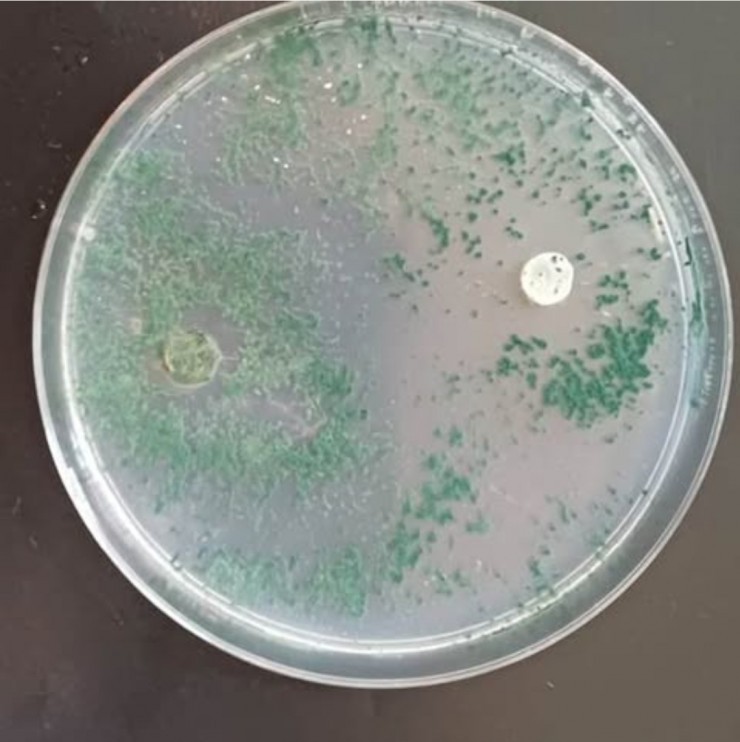

CIENCIA
La UNNE desarrolla hongos protectores que podrían impulsar el cultivo del caupí en Argentina
Investigadores de la Universidad Nacional del Nordeste trabajan en una técnica biológica con hongos beneficiosos que podría abrir la puerta a la producción masiva del caupí.
El caupí, una legumbre con alto valor nutritivo pero poco difundida en el país, enfrenta graves problemas por enfermedades que destruyen sus plantas. Investigadores de la Universidad Nacional del Nordeste trabajan en una técnica biológica con hongos beneficiosos que podría abrir la puerta a su producción masiva.
El caupí (Vigna unguiculata), también conocido como poroto caupí, es una legumbre con un enorme potencial alimentario: contiene hasta un 27 % de proteínas, aporta energía a través de carbohidratos y tiene un mínimo porcentaje de grasas. Además, se utiliza como abono verde, forraje y hasta para mejorar la fertilidad del suelo gracias a su capacidad de fijar nitrógeno.
Pese a sus virtudes, en Argentina todavía no se cultiva de manera masiva ni se comercializa extensamente. La razón es que, en las primeras etapas de desarrollo, el caupí es muy vulnerable a hongos patógenos del suelo —como Fusarium, Pythium y Rhizoctonia— que provocan la enfermedad conocida como damping-off. En muchos casos, esa afección destruye entre un 30 y 40 % de las plantas sembradas, lo que desincentiva a los productores.
Frente a ese obstáculo, un equipo de la UNNE trabaja en una estrategia innovadora: proteger las semillas con un hongo “guardián”. Se trata de Trichoderma, un género de hongos benéficos que ataca o inhibe a los patógenos dañinos.
El método que aplican, llamado biopriming, consiste en hidratar las semillas de caupí en una solución con esporas de Trichoderma. De esta forma, antes de entrar en contacto con el suelo, las semillas ya quedan recubiertas con un “escudo biológico” que mejora su capacidad de germinar y resistir enfermedades.
La investigación está a cargo del estudiante de Ciencias Biológicas Alejandro Camors, junto a los ingenieros agrónomos Alfonso Lovato Echeverría y Melanie Gómez Herrera, en articulación con el INTA de El Sombrero, Corrientes, donde ya se puso en marcha una planta piloto para transformar el caupí en harina y darle valor agregado.
Si bien aún falta comprobar la eficacia de la técnica a gran escala y su viabilidad económica, los resultados preliminares son alentadores. Para los investigadores, este avance podría ser la clave para que el caupí deje de ser una legumbre “promesa” y se convierta en una alternativa real para la producción familiar y la seguridad alimentaria en Argentina.
 Telegram
Telegram